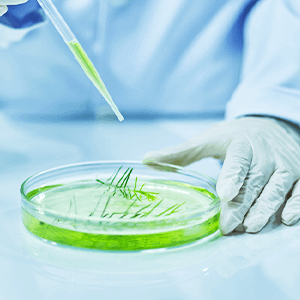
TF植物萃取複合物

Liver Care Life BALANCE
不只是日常保養,更是生活的後盾
在日常生活中,我們的身體默默運作,承擔著繁忙與挑戰。
面對長時間工作或生活節奏的不規律,維持身體機能的穩定運作顯得格外重要。
do you struggle with these issues?
您是否也關注身體的健康維持?
忙碌生活不等人,工作與生活步調可能影響您的氣色與精神狀態。這些都是日常生活帶來的小提醒。

生活不規律、熬夜應酬、感到疲倦、缺乏活力

皮膚黯淡、沒有光澤

壓力大、心情緊繃

睡眠品質差、容易疲累、情緒波動
Ignite energy spark your flow
開啟你的動力光,讓日常生活更有活力
從營養到健康,從內而外,給自己更多呵護與照顧
以穀胱甘肽為核心成分,搭配薑黃、朝鮮薊等多重植萃,
協同配方設計,讓日常保養更貼近生活需求



榖胱甘肽GSH
薑黃提取物
朝鮮薊、橄欖果、TF植物萃取物
硒酵母
複方維生素C
WeiWei
威威日常活力配方 | 長效支持 × 健康輔助
幫助維持日常活力,支持身體新陳代謝
設計為日常生活中的健康保養,協助忙碌生活中維持活力與健康
結合多重植萃與營養成分,採用專業原料來源,支持日常營養補給與健康管理。
以穀胱甘肽為核心,搭配薑黃、朝鮮薊等成分,為忙碌的生活提供更多的支持。
- 幫助維持日常健康狀態,支持身體正常運作。
- 為長時間工作和生活提供舒適感,支持日常活力。
- 支援清新感覺,保持充沛精神狀態,提升生活品質。
- 提供穩定的日常保養,協助調整體質,維持健康平衡。
需要的族群
長時間工作者
注重保養體態者
關注皮膚保養者
注重健康管理者
※ 無藥性食品,適合日常保養,支持身體活力與健康。
成分優勢

榖胱甘肽
有助於維持身體的日常健康,並支持抗氧化功能,幫助健康與活力。

薑黃提取物
薑黃素以其良好的生物利用率,協助維持身體健康,並支持身體自然平衡與新陳代謝。

朝鮮薊萃取物
成分:朝鮮薊萃取物、玉米麥芽糊精。
助於維持身體健康,支持正常的生理機能運作。

橄欖果萃取物
成分:麥芽糊精、橄欖果萃取物(含羥基酪醇)磷酸鈣。
支援抗氧化過程,幫助維持肌膚的自然光澤,並支持整體健康。
TF植物萃取複合物
成分:金頂側耳萃取物、刺芹側耳萃取物、酵母發酵物、蕎麥苗粉、綠茶萃取物。
由多種植物成分組成,協助維持身體保護力,支持健康的日常生理狀態。

硒酵母
提供抗氧化支持,協助維持身體健康與內部平衡。

複方維生素C
成分:抗壞血酸(維生素C)。
支持身體的抗氧化功能,幫助維持活力與整體健康。
這不是一般的B群,而是專為支持能量管理設計的配方。幫助維持健康代謝,維持氣色、活力與自然平衡。
WeiWei Flow Better Live Better




專為現代人忙碌生活設計的日常營養配方
結合穀胱甘肽、薑黃與朝鮮薊等多重植萃成分,幫助支持代謝與循環,維持身體健康,並提供營養補給。為忙碌的生活提供支持,讓你在繁忙的日常中,能夠保持穩定的狀態與自然的活力。

健康代謝

維持活力

營養補給

日常保護支持
Who is it for?
誰適合吃WEIWEI?
現代生活中的許多人,都可以從WEIWEI威威中獲得支持。從內而外幫助維持健康的代謝機能,提供穩定的精力和體力,支持忙碌生活中的日常需求。

工作、生活步調快,覺得體力跟不上。
體力不支

工作、課業量大長時間用腦,壓力大。
長時間用腦、壓力大族群

擔心日常生活中對肝臟的負擔,想要進行日常護肝保養。
肝臟保養

免疫力較低,容易感冒。
身體虛弱

熬夜、作息不穩定,常常需要外出應酬,想要幫助維持身體健康與順暢代謝。
生活不規律

感到口乾、口氣不清新。
口氣不佳

經常感到疲倦,壓力大,晚上容易失眠。
身體倦怠

希望維持亮白的氣色與健康的肌膚狀態,改善膚色不均的困擾。
改善膚況

關注肝臟健康想日常保養。
身體保養

關注新陳代謝健康,維持健康體態的人。
改善新陳代謝者

How to Use
食用建議
忙碌型
建議每日睡前2顆,可搭配水分。
強效保養型
建議每日早晚各2顆,搭配充足水分。
基礎保養型
建議每日睡前1-2顆,搭配水分食用。


weiwei Q&A
Custom Bundle
搭配建議 · 客製化組合










